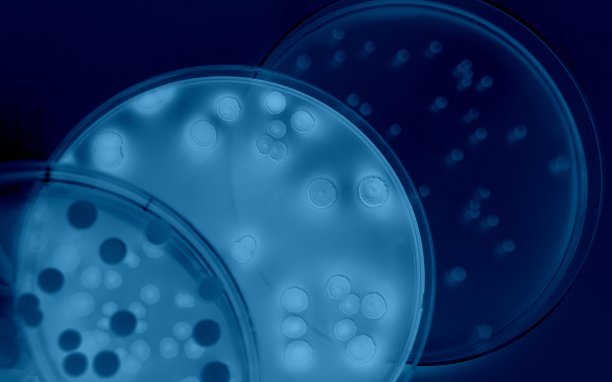
如何造就草莓上的微生物

本文目录导航:
如何造就草莓上的微生物,是未知的微生物,造就基须要
Ⅰ(1)启动植物微型繁衍时常驳回茎尖或根尖作为外植体,要素是茎尖或根尖病毒极少,因此切取必定大小的茎尖或根尖启动组织造就,再生的植株就或者不带病毒.(2)MS造就基的成分关键包含水、无机盐、无机小分子物质以及植物激素等.另外经常须要减少植物激素诱导植物细胞决裂、分化;外植体边缘部分污染,说明消毒不彻底.(3)不同植物激素的比例影响植物细胞发育方向,成长素与细胞决裂素的比值高时,无利于根的分化、克服芽的构成,比值低时,无利于芽的分化、克服根的构成. Ⅱ①本题中配制造就基的目标是选用造就合成玉米淀粉的高产菌株,因此要用固体造就基.造就基的碳源为玉米淀粉. ②将家养菌株接种到灭菌的造就基平板上. ③用紫内线照耀,诱导家养菌株出现基因突变. ④突变是不定向的,而要选用的变异菌株应该是能充沛合成玉米淀粉的类型,可经过加碘液启动检测,合成淀粉才干强的变异菌株所构成的菌落加碘液解决后,菌落周围的色彩浅,变色范畴较大,再经分别,纯化可取得所需的高效变异菌株.故答案为: Ⅰ(1)茎尖、根尖 不含病毒 (2)无机物 植物激素 外植体消毒不彻底(3)造就基中成长素类物质和细胞决裂素类物质用量的比值偏低. Ⅱ①固体 玉米淀粉 ②家养菌株 ③对家养菌株启动诱变 ④(透明圈)淡色范畴大
细菌是如何成长繁衍的
细菌的成长繁衍环节关键包含三个阶段:成长、决裂和构成新的集体。
首先,细菌在适宜的环境下开局成长,这是一个起始阶段。
随着期间的推移,细菌的数量开局逐渐增多,构成了菌落。
接上去是决裂阶段。
在这个阶段,细菌会经过自身的细胞壁启动决裂,将自身一分为二,构成两个新的集体。
这个环节理论在菌落构成后的一段期间内开局启动。
细菌细胞壁的决裂机制是细菌成长环节中的一个关键特色,也是细菌繁衍速度的关键要素之一。
最后是成熟阶段,这一阶段的细菌繁衍速度较慢,由于它们须要期间顺应环境并开展新的顺应性。
此外,细菌的成长繁衍还须要特定的条件,如适宜的温度、湿度和营养物质。
假设环境条件不满足或出现变动,细菌的成长繁衍或者会遭到克服或中止。
因此,环境条件对细菌的成长繁衍至关关键。
总的来说,细菌的成长繁衍是经过始终地决裂和顺应环境来成功的。
这一环节触及到许多复杂的生物化学和分子生物学机制,是微生物学钻研的关键内容之一。
微生物的繁衍模式有哪些
1、微生物繁衍模式分为无性繁衍和有性繁衍。
2、决裂生殖 是一个细胞决裂成2个或多个位置相反的细胞。
真菌是真核细胞型微生物,有典型的细胞核和细胞器,细菌是原核微生物,决裂生殖。
3、复制生殖:病毒无完整细胞结构,仅有一种核酸作为遗传物质,以复制的模式生殖。
4、出牙生殖 是在母体之上长出一个小的芽体,体积较小。
亲代藉由细胞决裂发生子代,在必定部位长出与母体相似的芽体,即芽基,芽基并不立刻脱离母体,而与母体相连,继续接受母体提供营养,直到集体可独立生存才脱离母体.是一种不凡的无性生殖模式,如酵母菌、水螅等腔肠生物、海绵生物等。
5、孢子升值,是经过发生无性生殖细胞孢子,再由孢子发育成一个全体.。
6、营养生殖,应该包含出芽生殖.另外植物的营养生殖就是扦插,压条一类的。